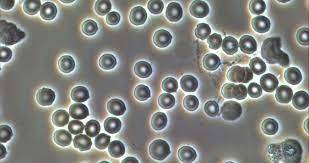

Bacterial cloning
Technique that scientists use to clone eukaryotic gene products in prokaryotic cells
Steps of bacterial cloning (5):
- Processes mRNA for eukaryotic gene of interest is located
- Processes mRNA is treated with reverse transcriptase to make cDNA (complementary DNA)
- Restriction enzyme and DNA ligase allow cDNA to be incorporated into plasmid (acts as a transfer vector in bacterial cloning)
- vector contining gene is taken up by competent bacterial cells
- Bacteria that took up vector undergoes transformation (cell genome is changed by addition of DNA from environment)
what is a vector?
A piece of DNA that can be taken up by competent cells. This allows the DNA to be replicated, transcribed into mRNA, and translated into protein.
FRAP
- (Fluorescence Recovery After Photobleaching)
- quantitative measure of how and where biomolecules are moving in a live cell
- determines whether a membrane protein can freely move around the membrane or if it is a structural component
- the entire cell is flourescently tagged
Steps of FRAP
- Scientist measures baseline (normal) fluorescene of sample
- An area of a sample is photobleached
- Due to cellular dynamics and the moving cytoplasm w/in the cell, photobleaached molecules are replaced by unbleached (fluorescent) molecules overtime
- Fluorescence of area is gradually restored and the recovery of fluorescence in a bleached area is measured, informing researchers about movment of membrane proteins
What is the purpose of photobleaching in FRAP?
Causes pigmented molecules to permanently lose fluorescence and allows for the quantitative measure of how and where bio molecules move in a live cell
What is the purpse of SDS PAGE?
Used to separate proteins by mass
What does SDS do to proteins?
SDS (sodium dodecyl sulfate):
* Denatures proteins
* Non-covalent bonds are denatured which causes protein to be linearized (allows protein to be in a non-native, unfolded state)
* Adds a negative charge to the proteins (negative charge is proportional to the proteins mass)
All of which allow for better electrophoresis through polyacrylamide gel
What are the proteins treated with in SDS PAGE?
Proteins are treated with primary and secondary antibodies
* primary antibodies will selectively bind to target protein
* secondary antibody will selectively bind to primary antibody (it will also glow a certain color)
Blunt ends
Do not have unpaired nucleotides, making them harder to hybridize
They are less common than sticky ends
Transgenic animals
Models that researchers use to identify function of a gene
How are transgenic animals used?
Gene sequence is taken from one organism and inserted into another organism through recombinant DNA technology
What do transgenic animals allow for?
Allow researchers to study the functional purpose of gene sequences
Allow researchers to mass-produce certian medications (ex: people with hemophilia need certain type of clotting factor)
Fluorescence lifetime
Refers to the amount of time it takes for an excited molecule to release all its fluorescence
Antibiotic resistance method:
- After restriction enzymes cut DNA, a gene that confers antibiotic resistance is attached to the target gene using ligase
- Only the cells that have (transformed) picked up and integrated the antibiotic resistance gene/target combo will have antibiotic resistance and will grow on a plate containing an antibiotic
- Cells that did not pick up this combo will die because they are not resistant to the antibiotic
If cell is still alive, gene of interest is present
Chromotography
Separates liquids in a mixture by solubility (differential solubility)
Color change method:
- Vectors containing a gene that make cells blue and restriction enzymes that cut the blue gene will be used
- If the target gene inserts (transforms) into the blue gene, the blue gene will be inactivated and the cell will appear its normal color (it turns white)
- If the target gene does not insert into the blue gene, the gene will reattach, remaining active and blue.
White = gene of interest is present
Scanning Electron Microscopy (SEM)
- Captures electrons that are scattered by atoms on the surface of dehydrated samples
- pro: allows for visualization of high resolution, 3D image of sample surface
- Con: costly and requires an extensive sample prep (kills sample because they are dried and coated)
SEM = Surface

Purpose of gel electrophoresis
To separate DNA, RNA or protein fragments by charge and size in agarose gel
What travels furthest towards the bottom of the gel in gel electrophoresis?
Smaller fragments or DNA (or RNA) travel further in the gel because the pores of gel obstruct the movement of larger fragments
Negatively-charged molecules (like DNA) will travel further in the gel because they want to move toward the positive anode at the bottom
Steps of gel electrophoresis
1) DNA is cut up into pieces by restriction enzymes
2) DNA is loaded into wells in the agarose gel (at the top of each lane)
* top of gel = negative cathode
* bottom of gel = positive anode
3) Electric field is applied to the gel
4) Negatively charged DNA will be attracted tot he positive end of the gel and smaller fragments will move further from the top of the gel
Pluripotent
- A stem cell can differentiate into any of the three germ layers: endoderm, mesoderm and ectoderm
- They can give rise to any cell type, but they cannot develop an entire organism because they can’t develop extra embryonic tissue, like the placenta
DNA fingerprinting
Identifies individuals through aspects of unique DNA, including RFLPs and STRs (short tandem repeats), group of nucleotides that repeats again and again in a stretch of DNA
Each individual has different RFLPs (except to identical twins)
Used in paternity and forensic cases
Phase contrast microscopes
- uses light phases and contrast for detailed visualization of thin samples containing live cells
Cells do not have to fixed, stained, or tagged because these microscopes have good contrast - Internal structures may be seen if cell layer is thin enough
- pro: good resolution and good contrast
- con: can’t use thick samples and may produce “‘halo effect” around. perimeter of sample